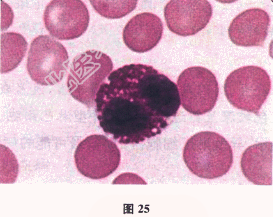

试题详情
- [材料题] 患者女性,35岁,无诱因出现双下肢红斑、丘疹,很快泛发全身,瘙痒感明显。全血细胞检查:RBC 4.10×1012/L,Hb 88g/L,WBC 8.29×109/L,PLT 246×109/L。
- 多项选择题1.镜检,如图25所示。细胞体积13~15μm,胞核2叶呈眼镜形,染色质粗糙,胞质内含橘黄色颗粒,颗粒粗大、整齐排列、均匀充满胞质。这是
A、嗜碱性粒细胞
B、中性晚幼粒细胞
C、嗜酸性粒细胞
D、单核细胞
E、中性粒细胞
F、淋巴细胞
关注下方微信公众号,搜题查看答案

- 多项选择题2.镜检分类结果显示,嗜酸性粒细胞33%, 绝对值2.74×109/L。经美能、钙剂静滴等治疗后,皮损渐退, 瘙痒缓解。患者可能的病因是
A、荨麻疹
B、寄生虫感染
C、嗜酸性粒细胞增多综合征
D、湿疹
E、肺部感染
F、传染性单核细胞增多症
关注下方微信公众号,搜题查看答案

- 多项选择题3.缓解半个月后,患者皮损再次发作, 且出现风团,全身水肿明显。查体: 神志清楚,慢性病容, 皮肤巩膜无黄染,全身浅表淋巴结未扪及。全身可见弥漫分布红斑, 双小腿中度水肿。患者还应做哪些进一步检查
A、变应原检测
B、皮损活检
C、自身抗体等免疫检查
D、寄生虫抗体相关检查
E、CT
F、B超
关注下方微信公众号,搜题查看答案

- 多项选择题4.结果显示:并殖吸虫IgG阳性, 患者感染的寄生虫是
A、旋毛形线虫
B、华支睾吸虫
C、猪绦虫
D、日本血吸虫
E、广州管圆线虫
F、肺吸虫
关注下方微信公众号,搜题查看答案

热门试题
- 女患,43岁, 血红蛋白55g/L,红细
- 戈谢病通常不常累及的组织器官是A、骨髓B
- 巨幼红细胞性贫血对,以下哪项是错误的(
- 属于纤维蛋白原降解产物为A、XYDE碎片
- 血小板形态与结构描述以下哪项正确A、不染
- APTT测定时应加入的试剂有A、白陶土、
- 外周血中中性粒细胞增高并伴有毒性改变常见
- 不符合β-地中海贫血杂合子的是( )。
- 女性,35岁, 面色苍白,牙龈出血, 月
- 下列符合慢性淋巴细胞白血病细胞化学染色特
- 1、该患者血沉结果为自动血沉仪所测得,关
- 促进血小板发生聚集和释放反应的强弱与以下
- 以下说法错误的是A、缺乏维生素K可引起因
- 红细胞破坏过多引起贫血,以下哪项是错误的
- 以下关于温抗体导致的自身免疫性溶血性贫血
- 以下哪一种疾病属于常染色体隐性遗传A、恶
- 评价检验结果的常用指标主要包括A、特异性
- 抗人球蛋白试验直接反应阳性,应该考虑A、
- 引起中性粒细胞增加的疾病为( )。A、
- 下列不符合正常骨髓象特征的是A、全片巨核